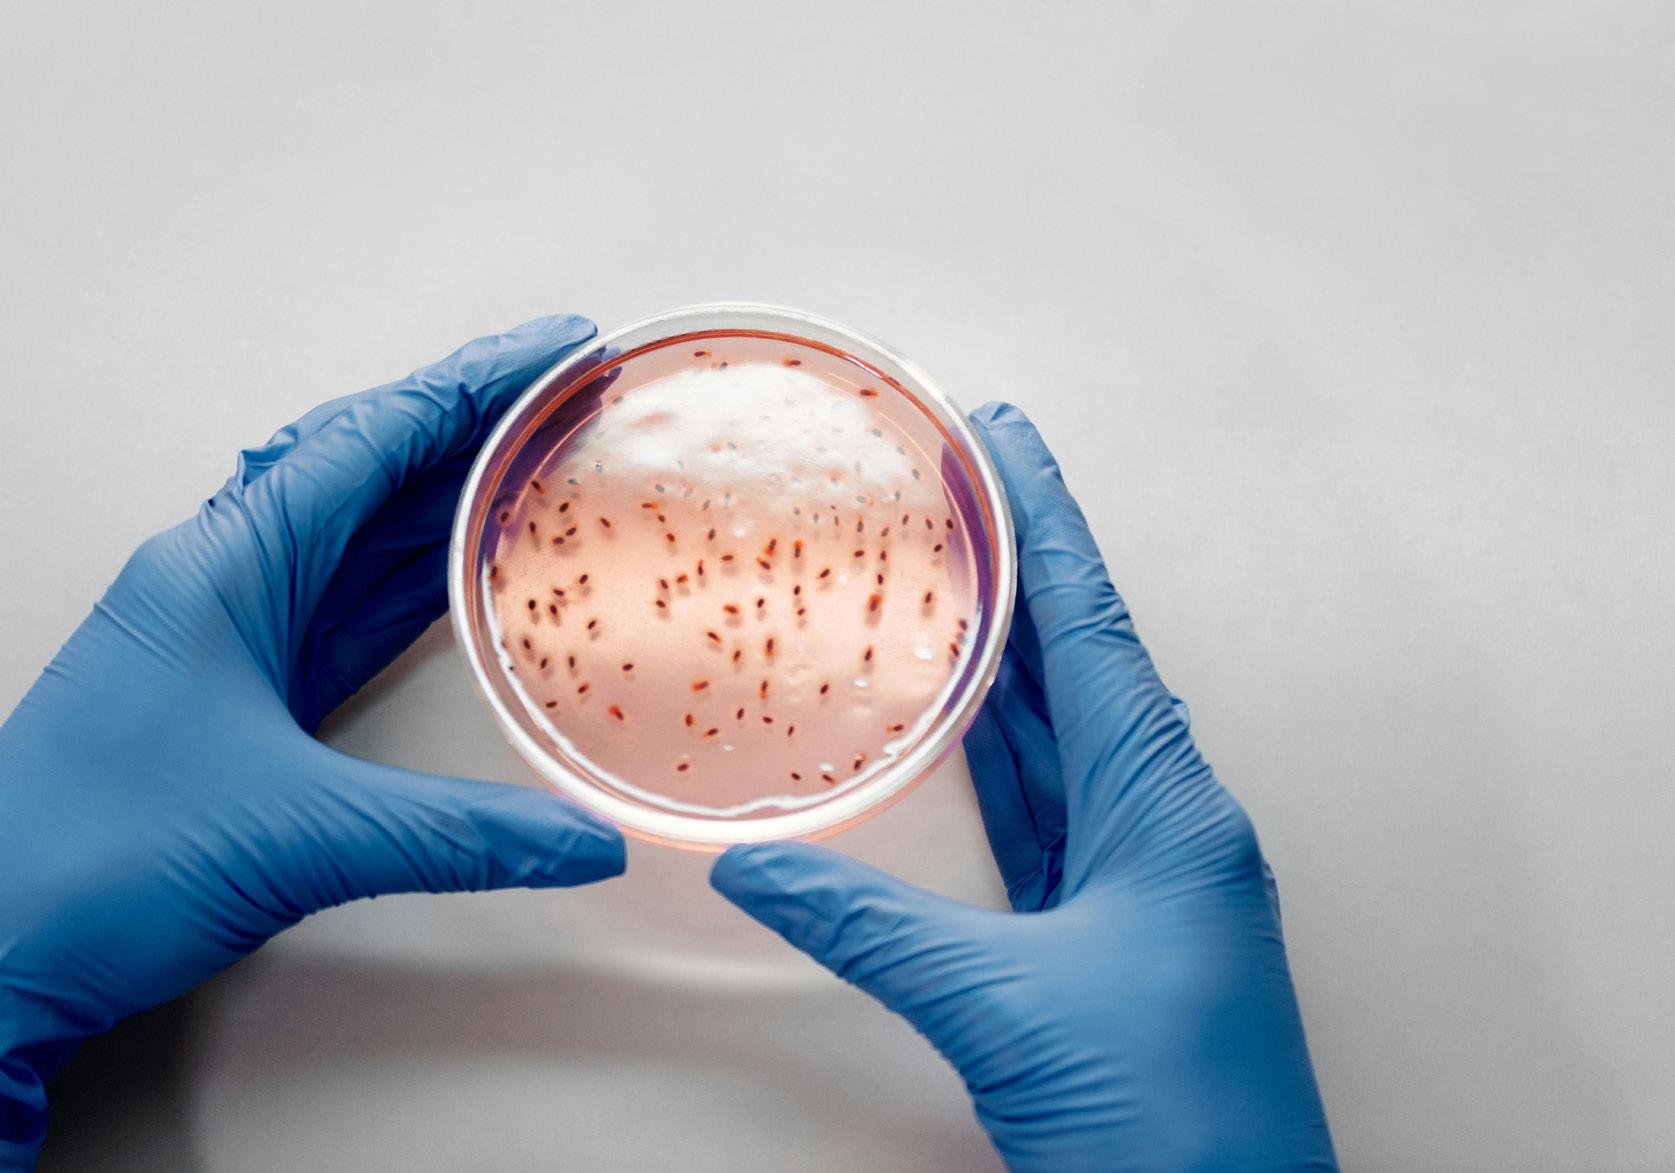

IMPACT
Philanthropy and Supporter
REPORT 2022-23

Cork University Foundation advances the strategic goals and objectives of University College Cork and the foundation’s primary function is to generate financial support for the university’s agreed priorities.
Cover: Lord Puttnam by Hero Johnson RP. Oil on canvas (100cm x 100cm). Collection of University College Cork.
Printed on 100% recycled paper
Photography (p. 3, 5, 8, 17, 27, 34, 37, 38, 40): Copyright UCC.
Contents
02 Foreword from the Chair
04 Message from the Director and CEO
06 Donor Roll of Honour
08 Thank you for your Support
Philanthropy Impact Stories:
10 Improving the Lives of Infants
12 Empowering Education: A Donor’s Experience
14 Lights, Camera, Action
16 Community Fundraising for Cancer Research
18 UCC Alumni Fund
20 A Class Act: Reunion Giving
22 Onwards and Upwards
24 A Gut Feeling
26 Promoting Access to Education
28 Matheson: Partnering to Innovate
30 Summer Smarts
32 Safeguarding Farmland Biodiversity
34 New Riverside Walk: The Cavanagh Way
36 Tribute to a Benefactor: Charles Francis Feeney
38 Catch-up on Campus
40 Board of Directors: Cork University Foundation
42 A Closing Note from the President
2022 2023
Foreward from the Chair
Together with the Cork University Foundation (CUF) Board, I am proud to introduce the Philanthropy and Supporter Impact Report 2022-23.
This edition highlights a collection of research, scholarship, student experience projects and more, that would not be possible without the generosity of our community.
It is my privilege to chair the CUF, a group of dedicated volunteers who work to promote specific fundraising initiatives that support our strategic plan, and who also cultivate a culture of philanthropy. While each individual project is transformational within the university, a culture of philanthropy has the power to influence society beyond the campus gates.
There is a particular story that I am passionate about within this report; one that encapsulates the breadth of impact that UCC has on teaching, learning and societal change: Promoting Access to Education.
It’s an ethos that spreads throughout the university and shapes a network of care in every school, department and office on campus. Equality, diversity and inclusion are
Cork University Foundation
critical to any thriving institution, but UCC prioritises these ideals through initiatives like the Access programme, which supports our students—particularly those from underrepresented backgrounds—as they navigate their educational journey.
This commitment to the university and our students is present throughout this publication. I hope you enjoy reading it as much as I did.
I am consistently humbled by the warmth and charity of the UCC community. On behalf of the board, thank you for your dedication to our shared future.
Neil O’Leary Chair, Cork University Foundation

Since its establishment in 1996, Cork University Foundation has assisted the university with its fundraising activities, helping maintain it as an internationally recognised university through the implementation of its strategic plan and the quality of its student experience, including excellence in teaching, learning and research.
2 IMPACT REPORT 2022-23

Message from the Director & CEO
Dear friends and supporters, a “culture of philanthropy” isn’t purely a fundraising concept.
Support of any kind—whether giving of your time, your funds, your partnership or otherwise—transforms the university and drives progress on campus and beyond. It leads to a chain reaction that permeates the community with a shared responsibility for our collective well-being. This sounds lofty, but it is true.
At UCC, we are building a culture of philanthropy every day, and you are a critical part of this.
Through your generosity, you are helping to continually reimagine UCC now and into the future. You are creating new research opportunities, improving patient outcomes, fostering creativity, achieving sustainability goals on campus, promoting access to education for students, preserving vital cultural collections, introducing innovative business partnerships, building community and so much more.
Giving is extremely personal. My team and I have spoken to so many alumni and friends,
each with their own unique reasons for supporting UCC and staying connected to this vibrant community. We hope to hear and share many more in the years to come.
The stories in this impact report highlight people, projects and programmes from last year that had a direct, immediate and lasting effect on UCC, but they are by no means the only stories. Every contribution—at any level—from a member of our community ignites positive change, creating a ripple effect that transforms lives and communities for a brighter, more resilient tomorrow.
Thank you for reading, and for all you do for the university.
Kerry Bryson
CEO, Cork University Foundation;
Director, Business Development & Advancement, UCC

UCC’s Mission
To create and sustain an inclusive environment and culture to enable transformative research and learning for the enrichment of society and stewardship of our planet.
4 IMPACT REPORT 2022-23

Donor Roll of Honour
The donor roll of honour recognises individuals, companies, foundations and trusts, who have supported UCC during the financial year, 1 October 2022 to 30 September 2023.
We would also like to thank our anonymous donors, those who have told us that they intend to leave the university a gift in their will, and those who volunteer their time to help the university in a number of different ways.
Thank you for your generosity and for supporting the university’s mission.
Every effort has been made to ensure this donor list is correct. If you think there is an error please contact foundation@ucc.ie
A&L Goodbody
Abbott Ireland
Adrian K Dixon
Adrienne M Kennedy
Affidea Ireland
Afolabi Ojo
Agricultural Trust
AIB Credit Card Services
AIB Group
Aidan & Elizabeth Synnott
Aideen H Hogan
Aimee E Millar
Aine F Ni Loingsigh
Aishling C O’Reilly
Aldi Ireland
Alison H Perrott
ALK-Abelló
Amy L Phelan
Andrew G Keating
Ang Gao
Ann Jago
Anna C Harris
Anne M Corcoran
Anne M McAuliffe
Anne M Murphy
Anthony Deevy
Anthony Muldoon
Aodhán R Floyd
Aoife C Granville
Aoife P Kiely
Apple
Arjun Nair
Arthur Cox
AstraZeneca
BA class of 1963
Babatunde Olotu Jubril
Bairbre Higgins
Bank of Ireland
Barry F Clinch
Bartholomew D Murphy
Becton Dickinson UK Ltd
Benjamin Koh
Bernardine M Rochford
Boston Scientific
Breakthrough Cancer Research
Brendan A Mullins
Brendan G Crowley
BrePco Pharma
Brian F Owens
Brigid O’Brien
Cadence Design Systems
Ireland Limited
Cancer Research @ UCC
Carbery Group
Caren E Baviera-Betson
Carmel H Sreenan
Carmel M O’Shea
Catherine Keohane
Catherine M Burke
Catherine Rosaline O’Neill
Cerebral Palsy Foundation (CPF)
Charles-Geoffrey Piron
Chiesi Farmaceutici
Christine M Harris
Christopher G Moloney
Ciara C McGlade
Ciara Harty
Civil Engineering class of 1998
Claire M Mansfield
Colin B Ross
Community Foundation Ireland
Comyn Kelleher Tobin
Conor & Mareta Doyle
Cook Medical Ltd
Cork Chamber
Cully & Scully
Dairygold Co-op Society Ltd
Daithi S O Rian
Daniel J Brosnan
Daniel J Troy
Daniel M O’Sullivan
Daniel T McCormack
Daragh and Anne Horgan
Darragh S Gogarty
David A Forrest
David A Walker
David Hogan
David J Ronayne
David M Giltinan
David M Slattery
David O’Callaghan
David T Cotter
Debbie Booker
Declan J Carey
Deirdre E Murray
Deirdre M Kiely
Deirdre Quinn
Dell EMC
Deloitte
Derek P Dunne
Dermot P McCarthy
Dervla Á Hogan
Devere Foundation, James P.
Diane McIntyre
Diarmuid A Kilcullen
Diarmuid Moloney
Diarmuid O’Donovan
Donal G O’Sullivan
Donal M O’Doherty
Dorothy M Barry
Douglas S Murray Éamonn A Ó Carragáin
Edel O’Connor
Edward C Cogan
Edward J Fitzgerald
Eli Lilly Kinsale
Elizabeth A Fitzsimons
Elizabeth A Stanley
Elizabeth M Dooley
Elizabeth R Beamish
Emer Howard
Emer R O’ Shea
Emily P Hunt
Emma E Denning
Emma J Tobin
Eoghan T Kelly
Eoin G McGrath
Eóin Mac Domhnaill
Eoin Murray Memorial Scholarship
Eugene N Clarke
Eugene O’Sullivan
FBD Holdings plc
FDC Group
Feileacean
FEXCO
Finbarr J O’Mahony
Finola M Cooney
Fiona E Russell
Fiona M Murphy
Fiona M O’Donnell
Fiona T Murray
Flavio A Cali
Florence V O’Mahony
Fondation Botnar
Frank Houttave
Gavin N Murray
GE Healthcare Ireland
Geraldine A Moynihan
Gerard D O’Sullivan
Gerard M O’Connor
Gerard P O’Hanlon
Gillian M Williams
Gina L Gogea
Glanbia
Goodbody Stockbrokers
Grainne M Hassett
Grunenthal Pharma Ltd
Gym + Coffee
H&MV Engineering
Hayfield Manor Hotel
Heineken Ireland
Helen M Boyle
Helen M Collins
Helen T Byrne
Helena Lynch-Stokes
Henrietta Therese McKervey
6 IMPACT REPORT 2022-23
Huawei Technologies Co. Ltd
HuiHui Lu
Inspiration Healthcare
Institute of Geologists of Ireland
IPSEN Pharmaceuticals Limited
Irene M Ryan
Irwin Green and Bethea Green
Support Foundation
J & G MacCarthy
Jacinta McCarthy
Jacqueline A Heal
Jacqueline M Sheridan
James B Tuohy
James J O’Shea
James J Stapleton
James M Crotty
Jane P Cahill
Janice M Crausaz
Janssen Pharmaceuticals
Jean M O’Donovan
Jennifer A Whyte
Jennifer D Mahony
Jennifer M Owens
Jeremiah P Ahern
Jeremiah P Twomey
John A Blackwell
John A Murphy
John A O’Donovan
John B McElligott
John B Rose
John C O’Connell
John C Riordan
John D Riordan
John F Murphy
John G Harrington
John G Kiely
John G Lyons
John G Madden
John J Desmond
John J Roche
John McCullagh
John McGuire
John O Larkin
John O’Halloran
John P Brennan
John P Connolly
John P Curtin
John P Kenny
John W Murphy
Josef And Anni Albers Foundation
Joseph A Clancy
Joseph O’Sullivan
Josephine N Ahern Loftus
JPA Brenson Lawlor
Julie M O’Connor
June P O’Connell
Karen Curtin
Karen M Tyrrell
Karen S Kelly
Katherine T O’Meara
Kathleen F Bambury
Kathleen M Ronayne
Kathy Dowling
Katie S Power
Keanes Jewellers Ltd
Kerry Bryson
Kerry Group Plc
Kevin Harkin
Kevin J O’Donovan
Kevin Power
KPMG LEO Pharma
Leslie and Eileen Quick
Linda P Fitzpatrick
Lingzi Zhou
Logitech
Lorraine A O’Donovan
Louis G Cooley
Louise A Walsh
Lucia J O’Donovan
Maire A Ni Dhalaigh
Maire F Kelly
Mairead T Downes
Maples Group
Margaret B O’Carroll
Margaret J Kent Landers
Margaret M Dunne
Margaret M O’Connor
Maria C O’Donovan
Maria D Kelly
Marie A O’Donoghue
Marie B O’Sullivan
Marie Kelleher
Marie S O’Donnell
Marietta Landers
Mark J O’Connor
Martin B Studdert
Mary A McCullagh
Mary C O’Donovan
Mary Dorgan
Mary F Fitzgerald
Mary G Buckenham
Mary J Lynch
Mary J Twomey
Mary Lavery
Mary M Devlin
Mary M Quinlivan
Mary P Higgins
Matheson
Matthew P McGrath
McCann Fitzgerald
Medicine class of 1982
Medtronic Ireland Limited
Michael A Bouchier
Michael C Hurley
Michael E Connell
Michael F O’Connor
Michael F Shanahan
Michael G Hoctor
Michael J Dowling
Michael J Duggan
Michael J Mackey
Michael J Willis
Michael Lyons
Michael P Mortell
Moog
Munster Agricultural Society CLG
Musgrave Group
Niamh McDonnell
Niamh O Regan
Noel J Tangney
Noeleen J Culbert
Noelle A Barry
Noelle T Dowling
Nora Connolly
Noreen M O Flynn
Noreen O’Leary-Kelleher
Norso Medical Limited
Oonagh C Kearney
Ornua
Oxygen Care Ltd OxyPrem
Pat & Mary O’Sullivan
Patricia Desmond
Patrick F O’Carroll
Patrick G Ryan
Patrick J Brennan
Patrick J Dineen
Patrick J Kennedy
Patrick J. J Quinn
Patrick P Collins
Patrick T O’Connor
Paul Fitzsimons
Paula M O’Callaghan
Peter B McCarthy
Peter J McNally
Pfizer Healthcare Ireland
Pfizer Pharmaceuticals
Production Corporation
Philip Nicholas Ryan
Phillip P Gostelow
Premier Surgical
Primacy Healthcare 21 Ltd
Provest Private Clients Ltd
PWC
Qualcomm
Rachel M Liston
Rathaspeck Golf Course
Raymond T O’Connor
RDJ LLP
Regina Fitzpatrick
Rethink Ireland (Social Innovation Fund)
Richard E O’Connor
Richard J Halpin
Ríon A Barry
Rita Naughton
Rory P Clune
Rosalie M Ní Mhaoldomhnaigh
Ruairi J Long
Ruth Cotter
Sachiko Inatomi
Sakina M Keohane
Saks Kavanaugh Foundation
Sarah A Coveney
Sarah J Clifford
Sarah M Murphy
Schubert Soares
Servier Laboratories (Irl) Ltd
Sharon M Kennedy
Sharon P Keohane
Sile A De Cleir
Simon J O’Keeffe
Sinead M Murphy
Siobhan C O’Connell
Siobhan McCarthy
Siobhan O’Sullivan
Sorcha S Ni Mhuimhneachain
Statkraft
Stephen L Stott
Stryker Ireland
Susan E Cronin
Susan Mary Patricia Curtin
Tesco Ireland
The Hospital Saturday Fund
The Liffey Trust
The Lifford Trust
Theresa Wilson
Thermo Fisher
Thomas A Jones
Thomas G Wrixon
Thomas John Horan
Thomas M Jones
Thomas M Moloney
Timothy Corcoran
Timothy Thaddeus O’Sullivan
TOMAR Trust
UPMC
Vivien A Fitzgerald-Smith
VMware International
Unlimited Company
Warren Rose
Wei Miao
Weston Family Foundation
WHH Foundation
William O Kirwan
William O’Brien
Windzor Pharma Limited
Xue Li
Yulia N Malitskaia
Yvelynne P Kelly
7 2022 2023
Gifts for today
€12.16m in new donations
Gifts for tomorrow

€4.31m in planned gift pledges
New assets to UCC
Chernobyl Children International Archive
Lord Puttnam Portrait
8 IMPACT REPORT 2022-23
Cork University Foundation thank you for your most generous support
UCC and
in 2022-23


359 Donors


Including123 new donors giving for the first time
Highlights

UCC Futures
€9.6m

Arts & Culture
€579k

UCC Alumni Fund
UCC Student Experience
€823K
Sustainable Futures
€375k

€160k

9 1427
G
ifts
Improving the Lives of Infants
Currently the most common lifelong physical disability acquired during childhood, cerebral palsy (CP) is diagnosed in around 150 children each year in Ireland. There are approximately 3,000 children and young people and 9,500 adults living with CP in Ireland today.
Early diagnosis of cerebral palsy in babies is crucial for significantly improving long-term outcomes.
The Cerebral Palsy Foundation’s partnership with UCC was announced last June when the non-profit global organisation awarded € 1.6 million in funding for CP education and research at UCC.
On World Cerebral Palsy Day in October, Professor Deirdre Murray was announced as Chair in Early Brain Injury and Cerebral Palsy at UCC. She is now leading research in early brain injury and cerebral palsy at the Irish Centre for Maternal and Child Health Research (INFANT), UCC with the objective of generating critical knowledge that will transform outcomes for children with cerebral palsy and their families.
The creation of this Chair in Early Brain Injury and Cerebral Palsy builds on an existing collaboration between the Cerebral Palsy Foundation and the INFANT Centre on
the “Early Detection and Intervention for Cerebral Palsy in Ireland” study. This is a national, multi-centre cohort study led by INFANT and coordinated by In4kids, the HRB Irish network for children’s clinical trials.
“The Cerebral Palsy Foundation looks forward to working with UCC and is so thankful for the funding it has received from donors to drive forward the CP Programme of Excellence in Ireland. We are excited that UCC will lead research and clinical care to change the trajectories of lives of infants with early brain injury and CP.
Rachel Byrne, Executive Director of the Cerebral Palsy Foundation

10 IMPACT REPORT 2022-23
”
Research and Innovation


Revolutionising Care
Professor Deirdre Murray’s appointment as Chair in Early Brain Injury and Cerebral Palsy is part of CPF’s programme of excellence which aims to revolutionise the delivery of cerebral palsy care in Ireland, making this country a leader for research into early brain injury.
Top (l-r): Carol Walsh, Head of Development, College of Medicine and Health, UCC; Lily Collison; Board Member, Cerebral Palsy Foundation; Rachel Byrne, Executive Director of the Cerebral Palsy Foundation; Kerry Bryson, CEO, Cork University Foundation. Above: Professor Deirdre Murray, Chair in Early Brain Injury and Cerebral Palsy. Photos by Fennell Photography.
Empowering Education: A Donor’s Experience
Ruth Cotter, BA ‘92 (Economics and History), is senior vice president at AMD (Advanced Micro Devices) in California, where she oversees Marketing, Communications and Human Resources. Ruth has been a donor to UCC since 2017, supporting projects from scholarships in creative writing to entrepreneurship initiatives. Alan Deasy, Head of Development, College of Business and Law caught up with Ruth to talk about third level education and why she supports UCC.
What inspired you to support your alma mater?
I believe that we are all products of our heritage and life journey so it’s important to me to give back in support of future generations to come. I applaud the work that the UCC team and students accomplish and recognise the positive influence they’ve had on my life. My time in UCC helped ground me in my career in business and set a solid foundation for future decisions. I am aligned with UCC’s culture of embracing differences and its journey of global inclusion and am delighted to make a very minor contribution to enable that journey.
Are there specific programs or initiatives that you are particularly pleased to support?
I’m particularly fond of supporting entrepreneurship, advancing women and writing skills.
Fostering and nurturing the Entrepreneurial Spirit has been foundational to my development. UCC’s marquee approach can help you refine your understanding of business principles and develop specialised knowledge in areas such as marketing, finance, and management. It teaches practical skills that can be immediately applied in real-life professional situations and strategies.
UCC is uniquely positioned to drive change, particularly by creating opportunities for
women and under-represented communities. I am delighted to support the advancement of women and wish to inspire those in areas they serve to pursue positively differentiated professional careers and lifelong opportunities.
I’ve found throughout my career that creative writing is so important for several reasons. Creative writing helps improve overall communication skills. Individuals must use language effectively to convey their ideas, emotions, and experiences in a way that captivates and engages the reader. It also requires you to think critically and creatively, come up with new and interesting ideas, and develop your own voice and style. This can help improve problem-solving skills, as well as enhance imagination and creativity.
Can you share a memorable moment or achievement at UCC that you are particularly proud to have been part of through your support?
I am delighted to continue to watch and participate in UCC’s dedication to fostering an entrepreneurial spirit through the IGNITE Entrepreneurship Programme. This flagship initiative has become a beacon for aspiring entrepreneurs, providing them with invaluable resources, mentorship, and access to a vibrant entrepreneurial ecosystem. IGNITE has witnessed a surge in successful ventures, further solidifying UCC’s position as a leader in fostering innovation and economic development. It outputs highly
12 IMPACT REPORT 2022-23
Student Success
qualified entrepreneurs into the world, fosters the spirit of “go for it” and encourages students to run towards some of the world’s toughest problems which uniquely positions UCC’s standing among some of the finest entrepreneurial institutions in the world.
What advice do you have for others considering philanthropic involvement with UCC?
Giving back to the community that helped shape you and your career provides such a sense of fulfillment and gives you an opportunity to make a meaningful impact on the lives of current and future students. It also allows you to contribute to opportunities
that can help students succeed, such as scholarships, research funding, and academic programme support. Your contribution can touch the lives of so many, and enable more people to pursue higher education, regardless of their financial situation – and that is a wonderful thing!
“ I am delighted to support the advancement of women and wish to inspire those in areas they serve to pursue positively differentiated professional careers and lifelong opportunities.
”

13
Ruth Cotter
Main: Alan Deasy and Ruth Cotter pictured at the Benefactors’ Lunch at UCC. Photo by Emma McCarthy.
Lights, Camera, Action
The Lord David Puttnam Scholarship programme supports collaborative film projects for UCC students. It was established by Lord Puttnam, a pioneer in digital education and producer of acclaimed films such as Chariots of Fire and The Killing Fields.
In addition to individual financial support, the programme provides each student with a unique opportunity to receive industry-level mentorship from Lord Puttnam along with seminars, coaching sessions, and team projects. Together, the students work to produce a film, which will then premiere at the annual Cork International Film Festival.
Each year, between six and eight scholars, from any academic discipline, are granted €1,000 each to support the advancement of their film projects.

Scan the QR code to watch a short video about the Puttnam Scholarship at UCC
As part of an outreach programme, transitionyear students with a passion for film making, met Lord David Puttnam and a host of film industry experts, at a special event in UCC in May 2023.
The students were participants in Screen Careers for Transition-Year Students, a new programme run by Atticus Education, the online education company chaired by Lord David Puttnam, and supported by UCC and Fís Éireann/Screen Ireland. It aims to introduce students to the vast opportunities that exist across Ireland’s thriving screen sector, and to help them better understand the medium of film.
“ ... the film industry in Ireland desperately needs bright and enthusiastic young people to see it as a viable and attractive career option.
”
Lord
Lord David Puttnam’s portrait has been donated to UCC Collections. The portrait (right) is an oil on canvas (100cm x 100cm), painted by Hero Johnson RP, a London-based visual artist.

14 IMPACT REPORT 2022-23
David Puttnam
Student Success
Opposite: Lord Puttnam (centre) pictured with Screen Careers for Transition Years students at UCC. Photo by Clare Keogh.

Community Fundraising for Cancer Research
A Night on the Plaza, an open-air concert held on campus last summer, raised over €33,000 for vital cancer research through ticket sales and additional generous donations from individuals and companies.
Sponsorship covered the costs for staging the concert, enabling 100% of ticket sales and additional philanthropic donations to go to Cancer Research @ UCC.
Roisin Connolly, the Professor Gerald O’Sullivan Chair in Cancer Research at UCC and Cork University Hospital, has been building bridges between university researchers and affiliated regional hospitals since her appointment in 2019.
Under her leadership, the CUH/UCC Cancer Centre will attain EU accreditation as a centre of excellence in the coming year. Roisin’s area of expertise is breast cancer clinical care and research.
Since 2006, UCC has hosted outdoor charity concerts which have become hugely successful, annual events on the music and social calendars of the city and region.
These spectacular, fully-seated, outdoor charity concerts, set in the beautiful surroundings of the UCC campus, draw audiences from across Munster each summer. Cumulatively, the concerts have already raised almost €800,000 for local and regional charities.
“
Our goal is to save lives through innovative research programmes, improving cancer outcomes and quality of life for patients. We are grateful to everyone who supported A Night on the Plaza in support of Cancer Research. Each donation will play a part in supporting our larger mission.
”Professor Roisin Connolly, the Professor Gerald O’Sullivan Chair in Cancer Research

16 IMPACT REPORT 2022-23
Research and Innovation


“
I am deeply grateful to the many volunteers from the UCC community and An Garda Síochána’s Community Policing who worked together to deliver this unique and memorable event. Together, we can make a meaningful difference in the lives of those affected by cancer and contribute to the advancement of medical research.
”
Pat
Cotter General Services Officer, UCC
Opposite: Cancer Research @ UCC being presented with a cheque for €33,121.50. Pictured (l-r) are Professor Roisin Connolly; Pat Cotter; Cal Healy, Deputy Director of Business Development and Advancement, UCC; Kerry Bryson, CEO, Cork University Foundation; Superintendent John Deasy (Community Policing and Community Safety); Mark Poland, Director of Buildings and Estates, UCC; Professor John O’Halloran, President, UCC. Top & Above: A Night on the Plaza audience enjoying an exciting and energetic concert celebrating the music and legacy of The Eagles with the sell-out band Dezperado, who were supported by local Cork musicians.
UCC Alumni Fund
Over the 2022-23 academic year, alumni around the world pledged €160,000 to the UCC Alumni Fund through two fónathons and other fundraising events and donations.
The UCC Alumni Fund finances projects which do not already receive government funding. These projects include the integration of extracurricular activities, campus life and diverse support services which contribute to a wellrounded university experience for UCC’s students. Projects and initiatives supported include:




Bolstering UCC’s mental health services by funding Student Counselling and Development’s expansion of out-of-hours support.
Providing funding for work in support of the National Student Mental Health and Suicide Prevention Framework and the Framework for Ending Sexual Violence and Harassment in Irish Higher Education Institutions.


Assisting asylum seekers and refugees to pursue further education in a welcoming and inclusive environment through the UCC Sanctuary Scholarship programme.

18 IMPACT REPORT 2022-23
Student Success
Thank you!
Co-funding UCC’s upcoming implementation of the SafeZone app, a mobile and desktop software application that increases the ease and accessibility of emergency calls, campus safety communications, anonymous tip reporting, and more.
Underwriting the costs of the UCC Student Forum, a citizens’ assembly that puts students at the heart of important strategic and policy issues facing the university community.



Funding the UCC Peer Support programme’s development, professional implementation and training of services tailored to students with autism.



Furnishing a new, open learning environment, known as the MakerSpace, with a focus on experimentation, collaboration, volunteerism, activism and diverse support services.


The UCC Alumni Fund also supported the Boole Library’s purchase of an historic hand painted watercolour map of Cork by military engineer Wolfgang William Romer (1640-1713). The map is significant for its depiction of Cork’s early topographical development at a crucial moment in the city’s history.

Main: Students callers for the 2023 Fónathon pictured with UCC President Professor John O’Halloran. Photo by Daragh McSweeney. Far left: Fiona Kennedy, Head of Student Counselling and Development. Far right: Angela Flynn, Chair of UCC Sanctuary Committee. Clockwise from top: Students’ Union representatives Aoibhe O’Brien and Jill Mortell; Louise O’Connor, Conservator, Boole Library; Gary Mulcahy, Head of Student Life at UCC with Peer Support Student Leaders Saoirse Coffey and David Meagher. Photos by Ger McCarthy.
19
A Class Act: Reunion Giving
Reunion classes who met during the 2022-23 academic year were invited to contribute a class gift to the UCC Alumni Fund.
Classes took the opportunity of donating surplus funds from their reunion ticket prices, while some graduates made additional donations in honour of former classmates who have passed away.
The UCC Alumni Fund supports and enhances all aspects of UCC’s university experience for students where grants are made to student groups such as sports clubs, societies, music groups, theatre productions, student conferences and community outreach projects.
“
It was lovely to stroll along my old stomping ground for the day, and to be taken by the hand, so to speak, over all those areas - the Dairy Science Theatre, the Rest, the Quarry, the Quad - was nectar to me.
Denis Lynch Dairy Science Class of 1963


20 IMPACT REPORT 2022-23
”
Student Success
Then... ... and Now!
Above: A photo of the BA Arts graduation in 1963. Main: The BA Arts Class of 1963 on campus at their recent reunion to celebrate 60 years since their graduation. Photo by Shane Horan.



In 2022-23, classes got together for their reunions and in addition to having a good time, they raised valuable donations for the UCC Alumni Fund.

21
BDS 2011
1973 Golden Jubilee
Medicine 2012
Onwards and Upwards
A glimpse behind the scenes at how philanthropic support can enhance, protect and encourage students’ experiences at all stages of their educational careers.

Helping start-ups find their feet
This is the motto of The Liffey Trust, who have established the Dr Seamus Mc Dermott Entrepreneurial Scholarship at UCC. Named for the founder of The Liffey Trust, who has helped establish more than 300 small businesses in Ireland, the €9,000 bursary is awarded to a first-year undergraduate in any discipline in UCC who will use the funding to further their entrepreneurial career. Successful scholars are encouraged to meet and collaborate with McDermott Entrepreneurial scholars in other Irish universities.
Supporting international medical students
Dr Arjun Nair, a Consultant Radiologist with University College London Hospital, has set up the Ananth Nair Memorial Fund, a bursary to support international medical students who are experiencing acute hardship due to extraordinary circumstances.
Dedicated to his brother, Ananth Nair, who sadly passed away from a sudden illness while studying Medicine at UCC, the bursary will continue his brother’s remarkable legacy of helping those who are most in need. 2023 marked the 25th anniversary of Ananth’s passing.

22 IMPACT REPORT 2022-23
Student Success
Above Left (l-r): Cal Healy, Deputy Director of Business Development and Advancement, UCC; Aidan Corless, Chair of the Liffey Trust. Above Right: Dr Arjun Nair pictured with his wife Gopika Nair and their daughter Ariana on a visit to campus.
Sharing her musical gifts through teaching
Mollaí Gough is the 17th recipient of the Staf Gebruers Annual Memorial Award for excellence in Music. The award of €3,000 is made to a final year music student to support their postgraduate studies in music or in a music related subject.
Mollaí, who is a fluent Irish speaker, is now taking a Professional Master of Education degree at UCC with her teaching placement based in Gaelcholáiste Mhuire A.G. in Cork City, teaching Music through Irish.
Staf Gebruers was carillonneur, organist and choirmaster at St. Colman’s Cathedral, Cobh from 1924, and for almost 50 years played a major role in the musical life of Cork and of Ireland. The €3,000 award is kindly sponsored by Ann Jago on behalf of her late husband Tom, a former student of Staf Gebruers.
“I grew up above my parents’ business, a pub in Dungarvan, and my dad is a traditional Irish musician from An Rinn, Gaeltacht na nDéise. I was introduced to Music at a very young age, meeting the most well known Irish musicians when they would play in the pub. I feel that my upbringing gives a unique perspective to my teaching and may inspire my students to learn more about our language, culture and the opportunities that can arise from them. I am eternally grateful to Ann Jago for helping me to embark on this journey.

23
Mollaí Gough
Members of the Gough, Gebruers and Jago families and friends at the award giving and celebratory lunch. Back row (l-r): Dr Jeffrey Weeter, Senior Lecturer, Department of Music, UCC; P.J. O’Brien; Helena Gough; Donnchadh Gough; Cathal Dorgan, Mary O’Brien; Declan Scott, Aideen Hogan, Communications Manager, UCC; Dr Declan Kennedy. Front row (l-r): Dr Liz Gebruers; Mollaí Gough; Ann Jago, Chev Adrian Gebruers; Finnualla Scott.
A Gut Feeling
Ever had a gut feeling? Professor John Cryan and his colleagues are challenging the very essence of this phrase. As a TedMed and TedX speaker he is a global leader in neuroscience research where he is literally turning our understanding of brain function upside down. Eimear Keohane, Associate Director of Advancement, talks to John about his work at UCC and the impact of philanthropy on his research.
How does your research help us to understand the critical relationship between the gut and the brain?
The work of our very multi-disciplinary team is focused on unravelling the pathways of communication between the gut (and especially the trillions of microorganisms that inhabit it; known as the microbiome) and the brain at key windows across the lifespan. Our discoveries in this area have been a complete paradigm shift in neuroscience. Indeed, the concept of a neuroscientist focusing on gut microbes was almost completely alien until our group’s discoveries started to emerge more than 15 years ago. We have shown that the microbes in the gut play a key role in brain development and healthy brain ageing. The implication of this work has relevance to a variety of disorders ranging from autism spectrum disorder, ADHD, anxiety and depression to Alzheimer’s and Parkinson’s Disease.
What are the key challenges facing your research at the moment?
There are two big areas where our attention is focused on – first can we translate any of the amazing findings we have made in animal models to humans in both health and disease. Secondly, our lab is heavily focused on dissecting the causal mechanisms of communication between the gut and the brain. We are also using state of art system neuroscience tools to understand the circuits in the brain that are sensitive to gut signals. This will be important in convincing the neuroscience field of the importance of such pathways.
How does philanthropy enable your work?
Given that our work is going against dogma in neuroscience, where traditionally scientists and clinicians are trained to focus on the neck up, philanthropy has allowed us to take on high risk-high gain projects that would fail to get funded by conservative funding bodies. We have been very fortunate in receiving private philanthropy from a variety of sources including the US-based Saks Kavanaugh and Bumpus Foundations as well another very significant US-based donor.
Moreover, charities such as the Weston Family Foundation are also an important source of funding for our research. Together, these initiatives are also key in training the next generation of creative and innovative PhD and postdoctoral scholars who will not be afraid to look at important research problems in a different way and perhaps turn dogma upside down too.
“
Funded in part through philanthropic donations, Professor Cryan’s research is focused on understanding the interaction between brain, gut, and microbiome and how it applies to stress, psychiatric and immune-related disorders. We are grateful for the generosity of our donors in furthering ground-breaking research like this.
Eimear Keohane Associate Director of Advancement, UCC
24 IMPACT REPORT 2022-23
Research and Innovation
”


Professor John Cryan’s research has been regularly featured in global news media and television, and soon in a Netflix documentary.
He is co-author of the bestselling book The Psychobiotic Revolution: Mood, Food, and the New Science of the Gut-Brain Connection published by National Geographic Press. He has published over 650 peer reviewed articles and is Principal Investigator in APC Microbiome Ireland research Institute in UCC.
Above: Professor John Cryan Photo by Clare Keogh.
Promoting Access to Education
Education plays a crucial role in the social, intellectual, cultural, economic, and political life of Ireland. Third level education is seen as increasingly necessary for a good quality of life and broader and more exciting career opportunities. Many groups and communities, however, are still under-represented at third level and in the university sector.
The Higher Education Access Route (HEAR) is a college and university admissions scheme which offers places on reduced CAO points and extra college supports to school-leavers from socio-economically disadvantaged backgrounds, who have completed an Irish Leaving Certificate. Additionally, through the Access UCC PLUS Programme, teenagers are mentored and supported at school and are encouraged to complete secondary school and develop a desire to attend third-level education.
More recently, philanthropic bursaries like the Dr Mary Barry Wall Bursaries are financially supporting students pursuing a career in teaching. These bursaries support students, who have completed an undergraduate degree in the humanities, in obtaining a Professional Masters in Education.
As a result of the targeted interventions, the number of students from socio-economically disadvantaged backgrounds entering UCC has increased from two in 1998 to 205 in
2022. In the academic year 2022/2023 a total of 747 students were supported.
“ At UCC, we believe there can be no better reward than enabling students to fulfil their potential. We want our students to be well-rounded, curious, self-aware individuals who continually embrace learning, welcome new ideas, and create positive change in the world.
”
Professor John O’Halloran President, UCC

Scan the QR code to watch a short video about how Access UCC PLUS supports alternative entry routes for UCC students

26 IMPACT REPORT 2022-23
Student Success


Equity in Education
Financial services firm
Provest has committed to providing two bursaries to help students complete their studies at UCC and hope to encourage other companies to follow their lead in breaking down barriers to education.
Above (l-r): Olive Byrne, Head of Access, UCC; Professor John O’Halloran, President, UCC; Mark O’Sullivan, Managing Director, Provest Private Clients Limited; Cal Healy, Deputy Director of Business Development and Advancement, UCC. Opposite: UCC students on campus. Image courtesy of UCC Access.
Matheson: Partnering to Innovate
Specifically directed at Law and Technology, the Matheson Innovation Partnership with UCC is supporting the creation of a new lectureship and PhD scholarship, as well as a series of lectures and collaborative events in law, technology, and innovation.
The five-year partnership, announced in March 2023, is designed to bring deep expertise in law and technology to the college, focusing on areas like artificial intelligence and disruptive technologies.
The Matheson Lectureship in Law, Innovation and Technology, and the associated PhD Scholarship, will provide much needed and mutually beneficial capacity to explore the legal implications of AI and disruptive technologies. Dr Neasa Lynch has recently been appointed as the Matheson lecturer, and will work with the PhD scholar to engage in interdisciplinary research in data analytics and computer science. This work will be aligned with the exciting UCC Futures programme, particularly the cluster relating to AI and data analytics.
Interdisciplinary research in fields such as data analytics and computer science will bring relevant teams together to develop an integrated and collaborative approach to meeting the latest technological challenges.
“
This partnership with UCC is an exciting opportunity to complement the work we are doing in our Digital Economy Group (a crossdepartmental team of specialists who cut through the complexities of digitalisation for clients) and to provide practical and commercial legal solutions in this fast changing digital environment.
”Michael Jackson Managing Partner, Matheson

28 IMPACT REPORT 2022-23
Research and Innovation


Students showcased their innovative thinking, creativity, and technical skills at the inaugural Matheson Hackathon. Participants combined legal, technology and business expertise to generate innovative ideas and explore emerging technologies.
Hackathon
Opposite and Top: Students take part in the inaugural UCC and Matheson Hackathon, 2023. Above: Professor Ursula Kilkelly, VP Global Engagement, UCC; Professor Mark Poustie, Dean of Law, UCC; Michael Jackson, Managing Partner at Matheson; Gráinne Callanan, Partner and Head of the Cork Office, Matheson.
Summer Smarts
The opportunity to study abroad offers students a taste of the culture they study as part of their degree programmes, broadening students’ perspectives through deeply immersive cultural experiences.
Devere legacy lives on UCC was delighted to welcome four students from Loyola Marymount University in California to its 41st International Summer School in Irish Studies in July 2023. Their attendance was kindly sponsored by Jay Grant and the James P Devere Foundation.
From the mid 90s, the late Irish American, James P Devere donated almost €3 million to UCC for various projects, and was honoured in the naming of Devere Hall, UCC’s student centre. James’ father Leo, who emigrated to America in the early 1900s, is also memorialised with a bronze bust sculpture which is displayed in UCC’s Kane Building and with the lecture theatres named in his memory.
The International Summer School in Irish Studies, enables students to enjoy a unique
learning experience by combining an introduction to major academic themes in the development of Irish identity with an opportunity to encounter Ireland’s rich cultural landscape.
Viva L’Italia Travel Bursary
The Lifford Trust “Viva L’italia Travel Bursary” enables up to six students a year to travel to Italy for a month in the summer where they can study the language and absorb the culture.
Established by the Lifford Trust, the annual grant of €9,000 funds up to six 1st and 2nd year students to take the opportunity to immerse themselves in an Italian experience. The bursary covers travel, accommodation and study courses.

“ I have contributed to UCC as a way of honouring my father. ”
James P Devere (quoted in The Graduate, Spring 1999).
30 IMPACT REPORT 2022-23
Student Success


“
Summer Schools offer international students a wonderful opportunity to enjoy an immersive experience in the culture they are passionate about studying. We are sincerely grateful to the philanthropic trusts and foundations whose support makes these enriching experiences possible for today’s students.
O’Driscoll Head of Development, College of Arts, Celtic Studies and Social Sciences, UCC
”
Oonagh
Top - back row (l-r): Oonagh O’Driscoll, Head of Development, UCC; Lia Patras, student; Aine Woods, student; Professor Stephen Byrne, Deputy President and Registrar, UCC; Isobel Smyth, student; Ronan Higgins, student; Dr Gabriella Caponi, University Language Teacher and Honorary Consul of Italy. Front row (l-r): Dr Silvia Ross, Head of School of Languages, Literatures and Cultures, UCC; Professor Daragh O’Connell, Head, Department of Italian, UCC; Dr Sara Lis Ventura, University Language Teacher. Photo by Tomas Tyner.

Safeguarding Farmland Biodiversity
Announced by Tánaiste Micheál Martin at the Cork Summer Show 2023, the Munster Agricultural Society (MAS) have made a generous philanthropic gift to the Cork University Foundation for the development of a Farmland Biodiversity Education and Research Programme within the Agricultural Science discipline at UCC.
MAS will also loan a two-acre research site to UCC for plot-based research in soil and grassland science. The site will provide valuable capacity for research to support the future sustainability and competitiveness of Irish pasture-based farming. This impactful contribution will be pivotal to the research being undertaken by Professor Frank Buckley.
The collaboration, in conjunction with the Environmental Research Institute will create and implement a comprehensive programme of farmland biodiversity education, demonstration, research and extension initiatives.
A lectureship post in farmland biodiversity funded by MAS will provide further leadership to the industry, guidance for future policy and incentive schemes, and
share with the public the positive actions being taken at farm level.
“
We are grateful for MAS’s support which will allow us to develop an exciting and much needed farmland biodiversity programme within Agricultural Science at UCC. It will also allow us to strengthen the delivery of our undergraduate and postgraduate teaching and cuttingedge research activity that will support the future sustainability of Irish grassland agriculture.
Professor Frank Buckley Head of Agricultural Science, UCC
”
Our Place, Our Footprint


“Ireland’s sustainable agricultural practices play a pivotal role in the Irish economy. This partnership will allow Ireland to continue to lead in terms of agricultural innovation, education and research for generations to come.
Tánaiste Micheál Martin
Above (l-r): Cllr Danny Collins, Lord Mayor of Cork County Council; Cllr Deirdre Forde, Lord Mayor of Cork City Council; Professor Frank Buckley; Tánaiste Micheál Martin; Robert Harkin, President of the Munster Agricultural Society; Saba Loftus, Head of Development, College of Science, Engineering and Food Science, UCC. Photo by Clare Keogh
New Riverside Walk: The Cavanagh Way

In honour of the late Tom and Marie Cavanagh, UCC has named its newest riverside walkway The Cavanagh Way. The naming honours the Cavanagh’s generous philanthropy to the university, which has had a transformative effect on the campus, its staff and its students.
The Cavanagh Way leads pedestrians along the banks of the River Lee - from the Alumni Bridge at the main UCC entrance, through the lower grounds, over The Cavanagh Bridge and across Gaol Walk. The route continues behind the Castlewhite apartments and on to the Western Gateway Building.
A new interactive biodiversity trail which runs the length of The Cavanagh Way has also been installed by UCC’s Office of Sustainability & Climate Action. The trail celebrates the nature found along the route and has been designed to be accessible for those who are new to wildlife watching, as well as those who are seasoned naturalists.
UCC’s riverside campus enjoys a diverse range of flora and fauna and is home to many mature native trees and shrubs. The riverbanks house native wildlife such as the common pipistrelle bat, grey wagtails and
treecreepers. These commonly found species, some of which are often overlooked, are illustrated to walkers on physical signage along the route of The Cavanagh Way.

Our Place, Our Footprint
Top: The Cavanagh Bridge and flower meadow at the university’s lower grounds. Above (l-r): Maeve Cavanagh O’Shaughnessy; Ronan Cavanagh; Professor John O’Halloran, President, UCC; Fiona Collier; Cal Healy, Deputy Director of Business Development & Advancement, UCC; Conor Cavanagh.
Photo by Ger McCarthy.



Scan the QR code to find out more about the biodiversity trail on The Cavanagh Way from UCC Green Campus
 Above & right: A map of the new biodiversity trail on The Cavanagh Way and some of the flora and fauna that can be seen along the route. Images courtesy of UCC Green Campus.
Above & right: A map of the new biodiversity trail on The Cavanagh Way and some of the flora and fauna that can be seen along the route. Images courtesy of UCC Green Campus.
Tribute to a Benefactor: Charles Francis Feeney
The Atlantic Philanthropies (Atlantic) were founded in 1982 by entrepreneur Charles ‘Chuck’ Francis Feeney (1931 – 2023) who decided to devote his wealth to the service of humanity. A champion of “Giving While Living,” Chuck maintained that people of wealth should use it to better the world during their lifetimes.
During his lifetime, the Irish-American gave away an estimated €6.5bn, over €2bn of that in Ireland. UCC, through the Cork University Foundation, benefited from close to €90 million between 1990 and 2006, from grants that were managed by Atlantic’s Irish office, Tara Consultants, based in Dublin. The gifts initially all were recorded as anonymous as since Chuck Feeney was keen to make his philanthropic gifts through private channels.
Chuck Feeney made major contributions to the university’s teaching, learning, and research endeavours. He also provided substantial funding for educational infrastructure in addition to land and property acquisition.
The physical impact of Chuck Feeney’s support can be seen across campus from the contemporary Western Gateway Building to the gothic style Department of Music on the north side of the river. His impact is also seen at Brookfield Health Sciences Complex, the Boole Library, BioSciences institute, the Environmental Research Institute, Mardyke Sports Centre and Nanoscience development at the Tyndall Institute.
The Centre for Gerontology and Rehabilitation at UCC is an example of the wide variety of projects funded by Atlantic. This centre facilitates interdisciplinary teaching and learning in gerontology, rehabilitation and end-of-life care through its postgraduate programmes.
Another initiative funded by Atlantic was the Evaluation of the Advancing Children’s
Rights objective in Ireland. This work has been instrumental in aiding the legal sector to improve advocacy for children’s rights.
Atlantic’s generosity transformed UCC beyond recognition. The university, its students and the wider community have benefited enormously from the support invested in its physical and academic infrastructure. The university is indebted to Chuck Feeney for making it all possible.
“Chuck Feeney was an inspirational leader of Irish and global philanthropy. The impact he had on higher education, research and innovation, helped generations of people in Ireland and beyond. I, like so many others in my profession, would not have my career without him. He was an inspiration to us all.
Kerry Bryson CEO, Cork University Foundation
36 IMPACT REPORT 2022-23
”


“
I cannot think of a more personally rewarding and appropriate use of wealth than to give while one is living — to personally devote oneself to meaningful effort to improve the human condition.
”Chuck Feeney (in a letter to Bill Gates)
Above: Chuck Feeney. Image courtesy of Atlantic Philanthropies.

Catch-up on Campus
Throughout the 2022-23 academic year, the
many positive developments. These four items offer a snapshot
progress and commitment to excellence.

Put your best paw forward
A service dog programme designed to enhance students’ positive mental health and help them to adjust to college life was launched in September 2023. Internationally, pet wellness programmes have been shown to act as an important mental health intervention on university campuses. Loneliness and homesickness are common challenges for university students, affecting their emotions, physical well-being, and academic performance.
Known as PAWS (Promoting Academic Wellbeing Supports), the programme is a collaboration between UCC and Cork based charity My Canine Companion.
Decade of Centenary commemorations
As part of the Decade of Centenary commemorations, RTÉ Cork in partnership with UCC produced a three-part documentary series
The Irish Civil War, based on UCC’s Atlas of the Irish Revolution. Narrated by Brendan Gleeson, this series tells the epic and often challenging story of the origins, conflict and legacy of the civil war. The series was broadcast on RTÉ during December 2022.

university experienced
of UCC’s ongoing
Our Place, Our Footprint
Above left: Professor John O’Halloran, President, UCC, pictured with the service dogs. Above right: The arrival of the Free State troops in Cork, 1922. Hogan-Wilson Collection. Image courtesy of National Archives of Ireland.

Ensuring victims and survivors will never be forgotten
The archives of Adi Roche and the Chernobyl Children International (CCI) charity have been acquired by UCC. The charity saved the lives of generations of children affected by the devastating impact of the 1986 Chernobyl nuclear disaster.
Artefacts, spanning over five decades, include radiation maps showing the spread of radioactive materials following the Chernobyl disaster; photographs; film; correspondence; pamphlets from the Irish Anti-Nuclear and Peace movements and Adi’s personal collection of records, including her Soviet gifted Chernobyl Liquidator Medal.


Sustainability Institution of the Year
The university won Sustainability Institution of the Year at the International Green Gown Awards 2023. The announcement was made as part of the United Nations High-Level Political Forum on Sustainable Development. Earlier in the year, the campus became plastic-free, eliminating the annual waste of 300,000 paper cups. UCC also established the first Sustainability and Climate Action office in Ireland’s higher education sector.
Above right (l-r): Professor John O’Halloran; Adi Roche; Coral Black, UCC University Librarian. Photo by Provision.
Above left (l-r): At the launch of the Sustainability & Climate Action Plan - Professor John O’Halloran; Dr Maria Kirrane, Head of Sustainability and Climate Action, UCC; Hayley O’Connell Vaughan, UCC SU Communications and Engagement Officer; Professor Brian Ó Gallachóir, Associate VP for Sustainability, UCC. Photo by Rubén Tapia.
Board of Directors
CORK UNIVERSITY FOUNDATION
“
It is my privilege to chair the CUF, a group of dedicated volunteers who work to promote specific fundraising initiatives that support our strategic plan, and who also cultivate a culture of philanthropy. ”
Neil O’ Leary Chair, Cork University Foundation
Scan the QR code to read our previous Impact Reports and find out more about the power of philanthropy at UCC


40 IMPACT REPORT 2022-23
The Cork University Foundation is incorporated in Ireland as a limited liability company and a registered charity:
Company
Chair
Secretary
Neil O’Leary CEO, Ion Equity
Nora Geary
Corporate Secretary, UCC
Ex Officio Professor John O’Halloran President, UCC
Directors
CEO
Independent auditors
Maeve Cavanagh O’Shaughnessy
John Fitzgerald
David Merriman
Honor Moore
Bill Murphy
Dr Dermot O’Mahoney
Aidan Synnott
Kerry Bryson CEO, Cork University Foundation Director of Business Development and Advancement, UCC
PricewaterhouseCoopers
Chartered Accountants and Statutory Audit Firm, One Albert Quay, Cork, Ireland
Bankers
41
243605
Registered Charity Number (RCN): 20033385
Registration Number (CRN):
|
Chartitable Tax Exemption Number: CHY11831
AIB 66 South Mall, Cork, Ireland
RDJ LLP 85 South Mall, Cork, Ireland
Solicitors
A Closing Note from the President
Thank you for reading this impact report and for everything that you do for UCC. Due in no small part to this community’s institutional pride and spirit of giving, our university is committed to changemaking research, providing a fulfilling education across disciplines, and delivering an outstanding student experience.
UCC is always forward-looking, and as we embark on the second year of our strategic plan, Securing Our Future: UCC Strategic Plan 2023–2028, I am reminded of everything we accomplished in year one. Three new strategic appointments - VP Global Engagement, Chief Finance & Operating Officer and Chief People & Culture Officerhave further strengthened our leadership to support us to deliver excellence now, and in the years ahead. The UCC Futures framework for research has advanced significantly this year, with the launch of five new thematic areas, bringing the total to nine areas now fully operational to enhance UCC’s research impact. This supports the delivery of excellence in research, as evidenced by significant research funding success this year, including three new European Research Council awards across science, law and the radical humanities.
I am also keenly aware of how much important work there is still to do. I am president of the university, but I am first and foremost an alumnus. I love UCC and I want to see it continue to thrive. Our strategic plan builds on our strengths and positions UCC optimally in an environment of rapid change, reflecting our commitment to a sustainable future for our people, our planet and our university.
Climate action; equality, diversity and inclusion; artificial intelligence; medical advances; preservation of arts, culture and heritage; and establishing innovative business partnerships are more than just hot-button issues. They are focal points for UCC as we grow our research strategically and continuously adapt our curriculum and learning opportunities beyond the classroom to prepare our students for the future world of work.
You—our alumni, friends and supporters—are critical to the future of UCC and to enhancing our reputation. Whatever your relationship with UCC, by mentoring, donating, connecting and celebrating UCC, you help the university to secure our future.
Thank you again. I look forward to continuing our work together and to further strengthening UCC’s place on the world stage.

42 IMPACT REPORT 2022-23

“
You our alumni, friends and supporters are critical to the success of the strategic plan. By mentoring, donating, connecting and celebrating UCC, you help the university secure our future.
Professor John O’Halloran President, UCC
”
44 IMPACT REPORT 2022-23
Notes
Further
Information
Further Information
If you have any queries, or would like to visit campus and learn more about UCC’s funding priorities, please contact any member of staff:
If you have any queries, or would like to visit campus and learn more about UCC’s funding priorities, please contact us at foundation@ucc.ie:
Kerry Bryson
Kerry Bryson
Director of Business Development and Advancement UCC.
CEO, Cork University Foundation
Director of Business Development & Advancement Alumni and Development, UCC
Cal Healy
Director of Development, Alumni and Development, UCC.
Cal Healy
Kate McSweeney
Deputy Director of Business Development & Advancement Alumni and Development, UCC
Deirdre O’Shea
Director of Communications, Alumni and Development, UCC. E: foundation@ucc.ie
Associate Director of Stakeholder Engagement Alumni and Development, UCC
Deirdre Stuart
Associate Director of Finance & Operations for Advancement Alumni and Development, UCC
45

Cork University Foundation, University College Cork (RCN No: 20033385)
UCC Educational Foundation (UK), University College Cork (Registration No. 1021681)
c/o Alumni and Development, University College Cork 2.12 Western Gateway Building | Western Road | Cork | T12 XF62 | Ireland E: foundation@ucc.ie | T: +353 (0)21 420 5403 | W: https://cufdevelopment.ucc.ie

Above & right: A map of the new biodiversity trail on The Cavanagh Way and some of the flora and fauna that can be seen along the route. Images courtesy of UCC Green Campus.
Above & right: A map of the new biodiversity trail on The Cavanagh Way and some of the flora and fauna that can be seen along the route. Images courtesy of UCC Green Campus.












